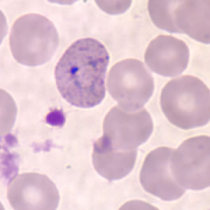
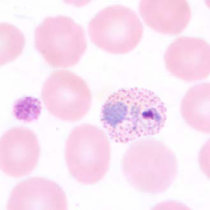
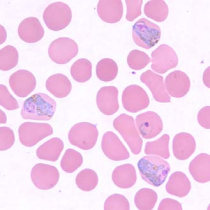
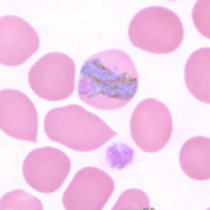
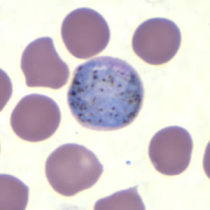
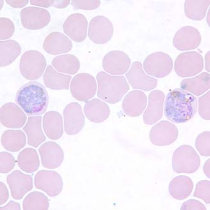
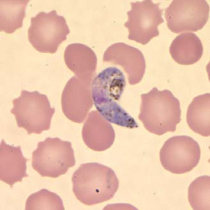
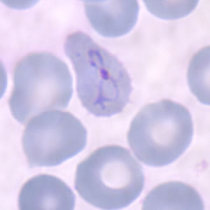
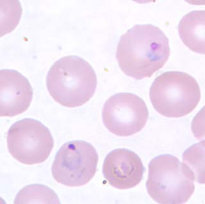
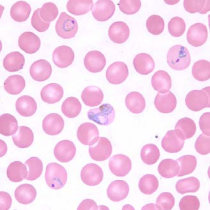
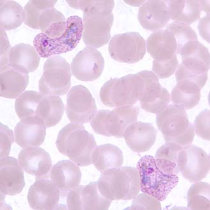
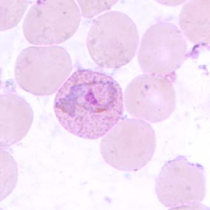
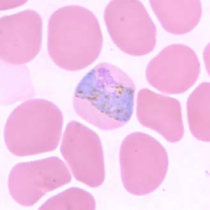
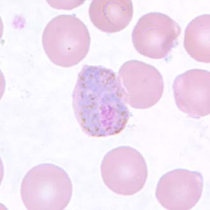
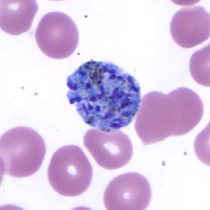
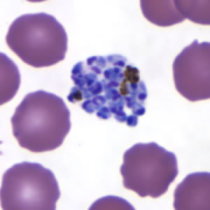

پلاسمودیوم ویواکس
اسپورداران
گلبولهای قرمز آلوده بزرگتر از معمول و دانههای شوفنر در گلبولهای آلوده به این انگل دیده میشوند.
راهنمایی های پایه:
- خون مویرگی باید از طریق سوراخ کردن نوک انگشت (فینگر استیک) یا خون وریدی از طریق خون گیری وریدی (ونیپانکچر) گرفته شود.
- اسمیرهای خونی، حداقل دو اسمیر ضخیم و دو اسمیر نازک، باید در سریعترین زمان ممکن پس از جمع آوری خون تهیه شوند. تاخیر در تهیه اسمیرها میتواند باعث ایجاد تغییر در مورفولوژی انگل و ویژگیهای رنگ آمیزی شود.
- نقاط شوفنر را میتوان با رنگ آمیزی گیمسا نشان داد که نسبت به رنگ آمیزی رایت یا رایت-گیمسا ارجحتر است.
در عفونتهای ناشی از پلاسمودیوم ویواکس، اندازهی گلبولهای قرمز، نرمال یا مقداری بزرگتر از حد نرمال (تا × 5/1 تا ×2) هستند و ممکن است تغییر شکل پیدا کنند. در شرایط ایدهال، نقاط شوفنر در لامهای رنگ شده با گیمسا مشاهده خواهند شد.
شکل حلقوی (رینگ فرم)
شکل حلقوی پلاسمودیوم ویواکس دارای نقاط کروماتینی بزرگ میباشد و سیتوپلاسم آنها به هنگام رشد میتواند حالت آمیبی مانند پیدا کند.
تروفوزوئیت
تروفوزوئیتهای پلاسمودیوم ویواکس دارای سیتوپلاسمی آمیبی مانند، نقاط کروماتینی بزرگ و رنگدانههای ظریف قهوهای مایل به زرد هستند. نقاط شوفنر در اینگونه از پلاسمودیومها ظریفتر از پلاسمودیوم اُوالی دیده میشود.
گامتوسیت
گامتوسیتهای پلاسمودیوم ویواکس گرد تا بیضی شکل، با رنگدانههای پراکندهی قهوهای میباشند و میتوانند تمام گلبول قرمز را پر کنند. نقاط شوفنر در این گونه، ظریفتر از پلاسمودیوم اُوالی ظاهر میشوند.
شیزونت
شیزونتهای پلاسمودیوم ویواکس بزرگ بوده و دارای 12 الی 24 مِروزوئیت میباشند. این شیزونتها حاوی رنگدانههای قهوهای مایل به زرد به صورت متراکم هستند و ممکن است کل گلبول قرمز را پر کنند.

 شیزونت پلاسمودیوم ویواکس
شیزونت پلاسمودیوم ویواکس
 تروفوزوئیت در حال رشد پلاسمودیوم ویواکس
تروفوزوئیت در حال رشد پلاسمودیوم ویواکس
 پلاسمودیوم ویواکس (شیزونت رسیده)
پلاسمودیوم ویواکس (شیزونت رسیده)
 تروفوزوئیت پلاسمودیوم ویواکس
تروفوزوئیت پلاسمودیوم ویواکس
 پلاسمودیوم ویواکس (ماکروگامتوسیت)
پلاسمودیوم ویواکس (ماکروگامتوسیت)
 تروفوزوئیت بالغ پلاسمودیوم ویواکس
تروفوزوئیت بالغ پلاسمودیوم ویواکس
 شیزونت رسیده (بالغ) پلاسمودیوم ویواکس
شیزونت رسیده (بالغ) پلاسمودیوم ویواکس
 رینگ پلاسمودیوم ویواکس
رینگ پلاسمودیوم ویواکس
 رینگ در اسمیر خونی ضخیم – هالهی موجود در کنارهها، نمایانگر نقاط شوفنر میباشد.
رینگ در اسمیر خونی ضخیم – هالهی موجود در کنارهها، نمایانگر نقاط شوفنر میباشد.
رینگ آمیبوئیدی در یک گلبول قرمز بزرگ و غیرطبیعی آلوده – نقاط شوفنر قابل رویت هستند.
رینگ آمیبوئیدی در یک گلبول قرمز بزرگ و غیرطبیعی آلوده – نقاط شوفنر قابل رویت هستند.
 به میزان بزرگ شدن گلبولهای قرمز آلوده توجه کنید.
به میزان بزرگ شدن گلبولهای قرمز آلوده توجه کنید.
 تروفوزوئیتها در اسمیرهای خونی ضخیم
تروفوزوئیتها در اسمیرهای خونی ضخیم
 تروفوزوئیتها در اسمیرهای خونی ضخیم
تروفوزوئیتها در اسمیرهای خونی ضخیم
تروفوزوئیتهای بزرگ و آمیبوئیدی در اسمیرهای خونی نازک – به حضور نقاط شوفنر توجه کنید؛ این نقاط با رنگآمیزی توسط رنگ گیمسا نسبت به رنگ رایت، بهتر قابل رویت خواهند بود.
تروفوزوئیتهای بزرگ و آمیبوئیدی در اسمیرهای خونی نازک – به حضور نقاط شوفنر توجه کنید؛ این نقاط با رنگآمیزی توسط رنگ گیمسا نسبت به رنگ رایت، بهتر قابل رویت خواهند بود.
این اسمیرها نشانگر تروفوزوئیتهای بالغ هستند – شباهت این سلولها را با فرم بند مانند پلاسمودیوم مالاریه بررسی کنید – بزرگ شدگی گلبولهای قرمز توسط پلاسمودیوم ویواکس به شما در تشخیص این دو گونه کمک میکند.
این اسمیرها نشانگر تروفوزوئیتهای بالغ هستند – شباهت این سلولها را با فرم بند مانند پلاسمودیوم مالاریه بررسی کنید – بزرگ شدگی گلبولهای قرمز توسط پلاسمودیوم ویواکس به شما در تشخیص این دو گونه کمک میکند.
این اسمیرها نشانگر تروفوزوئیتهای بالغ هستند – شباهت این سلولها را با فرم بند مانند پلاسمودیوم مالاریه بررسی کنید – بزرگ شدگی گلبولهای قرمز توسط پلاسمودیوم ویواکس به شما در تشخیص این دو گونه کمک میکند.
این اسمیرها نشانگر تروفوزوئیتهای بالغ هستند – شباهت این سلولها را با فرم بند مانند پلاسمودیوم مالاریه بررسی کنید – بزرگ شدگی گلبولهای قرمز توسط پلاسمودیوم ویواکس به شما در تشخیص این دو گونه کمک میکند.
گامتوسیت در اسمیرهای خونی نازک
گامتوسیت در اسمیرهای خونی نازک
یک جفت گامتوسیت در اسمیر خونی نازک
یک جفت گامتوسیت در اسمیر خونی نازک
 به بزرگ شدگی گلبولهای قرمز آلوده و پراکنده بودن رنگدانهها دقت کنید.
به بزرگ شدگی گلبولهای قرمز آلوده و پراکنده بودن رنگدانهها دقت کنید.
اُووکینِتها ممکن است هنگامی ایجاد شوند که خون با فاصله زمانی زیادی مورد بررسی و پردازش قرار گیرد.
اُووکینِتها ممکن است هنگامی ایجاد شوند که خون با فاصله زمانی زیادی مورد بررسی و پردازش قرار گیرد.
 شیزونت در اسمیر خونی ضخیم
شیزونت در اسمیر خونی ضخیم
 شیزونت در اسمیرهای خونی ضخیم
شیزونت در اسمیرهای خونی ضخیم
 شیزونت بالغ در اسمیرهای خونی نازک
شیزونت بالغ در اسمیرهای خونی نازک
 پلاسمودیوم ویواکس
پلاسمودیوم ویواکس
 پلاسمودیوم ویواکس (ماکروگامتوسیت)
پلاسمودیوم ویواکس (ماکروگامتوسیت)
 ماکروگامتوسیت پلاسمودیوم ویواکس
ماکروگامتوسیت پلاسمودیوم ویواکس
 تروفوزوئیت بالغ پلاسمودیوم ویواکس
تروفوزوئیت بالغ پلاسمودیوم ویواکس
 تروفوزوئیت آمیبی شکل پلاسمودیوم ویواکس
تروفوزوئیت آمیبی شکل پلاسمودیوم ویواکس
 شیزونت بالغ پلاسمودیوم ویواکس
شیزونت بالغ پلاسمودیوم ویواکس
 بـازوفیلیـک استیپلینـگ و رینـگ پلاسمودیوم ویواکس
بـازوفیلیـک استیپلینـگ و رینـگ پلاسمودیوم ویواکس
 تروفوزوئیت پیر پلاسمودیوم ویواکس
تروفوزوئیت پیر پلاسمودیوم ویواکس
رینگ آمیبوئیدی در یک گلبول قرمز بزرگ و غیرطبیعی آلوده
رینگ آمیبوئیدی در یک گلبول قرمز بزرگ و غیرطبیعی آلوده
رینگهای بیشتر در یک اسمیر خونی نازک
رینگهای بیشتر در یک اسمیر خونی نازک
رینگها و تروفوزوئیت در یک اسمیر خونی نازک
رینگها و تروفوزوئیت در یک اسمیر خونی نازک
 تروفوزوئیتها در اسمیرهای خونی ضخیم
تروفوزوئیتها در اسمیرهای خونی ضخیم
تروفوزوئیتهای بزرگ و آمیبوئیدی در اسمیرهای خونی نازک – به حضور نقاط شوفنر توجه کنید؛ این نقاط با رنگآمیزی توسط رنگ گیمسا نسبت به رنگ رایت، بهتر قابل رویت خواهند بود.
تروفوزوئیتهای بزرگ و آمیبوئیدی در اسمیرهای خونی نازک – به حضور نقاط شوفنر توجه کنید؛ این نقاط با رنگآمیزی توسط رنگ گیمسا نسبت به رنگ رایت، بهتر قابل رویت خواهند بود.
تروفوزوئیتهای بزرگ و آمیبوئیدی در اسمیرهای خونی نازک – به حضور نقاط شوفنر توجه کنید؛ این نقاط با رنگآمیزی توسط رنگ گیمسا نسبت به رنگ رایت، بهتر قابل رویت خواهند بود.
تروفوزوئیتهای بزرگ و آمیبوئیدی در اسمیرهای خونی نازک – به حضور نقاط شوفنر توجه کنید؛ این نقاط با رنگآمیزی توسط رنگ گیمسا نسبت به رنگ رایت، بهتر قابل رویت خواهند بود.
این اسمیرها نشانگر تروفوزوئیتهای بالغ هستند – شباهت این سلولها را با فرم بند مانند پلاسمودیوم مالاریه بررسی کنید – بزرگ شدگی گلبولهای قرمز توسط پلاسمودیوم ویواکس به شما در تشخیص این دو گونه کمک میکند.
این اسمیرها نشانگر تروفوزوئیتهای بالغ هستند – شباهت این سلولها را با فرم بند مانند پلاسمودیوم مالاریه بررسی کنید – بزرگ شدگی گلبولهای قرمز توسط پلاسمودیوم ویواکس به شما در تشخیص این دو گونه کمک میکند.
 گامتوسیت در اسمیر خونی ضخیم
گامتوسیت در اسمیر خونی ضخیم
 گامتوسیت در اسمیرهای خونی نازک
گامتوسیت در اسمیرهای خونی نازک
گامتوسیت در اسمیر خونی نازک
گامتوسیت در اسمیر خونی نازک
 اُووکینِتها در اسمیرهای خونی نازک
اُووکینِتها در اسمیرهای خونی نازک
 اُووکینِتها در اسمیر خونی ضخیم
اُووکینِتها در اسمیر خونی ضخیم
 شیزونت در اسمیرهای خونی ضخیم
شیزونت در اسمیرهای خونی ضخیم
شیزونت نابالغ در اسمیر خونی نازک
شیزونت نابالغ در اسمیر خونی نازک
شیزونت بالغ در اسمیرهای خونی نازک
شیزونت بالغ در اسمیرهای خونی نازک